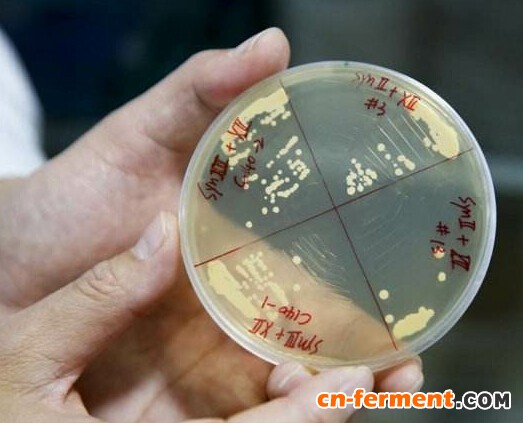

合成生物学领域又有重大突破。由、中、美、英、法等多国共同协作承担的“重新设计并化学合成真核生物酿酒酵母的全部16条染色体”的项目,目前已完成五条染色体的重新设计与合成,这预示着未来人类可以合成新的或者灭绝的物种。
“再造生命”新纪元
上周六凌晨,华大基因董事长、创始人汪建突然在微信群里宣布了一个重大消息:“第一个人工再造真核生命体已经在华大基因及其合作伙伴的实验室里实现了。这次是真核细胞,下回是动植物,再以后就是真人细胞了,上帝也要羡慕了。”
“合成生物学是继‘DNA双螺旋发现’和‘人类基因组测序计划’之后,以基因组设计合成为标志的又一次突破。实现了基因组‘读与写’的贯穿。”汪建说,“此次合成的真核生物酿酒酵母的全部16条染色体,共有1400万个碱基,大小约为人基因组的5%。”
该成果以封面的形式刊登在3月10日出版的国际顶级学术期刊《科学》上,4篇长文介绍了真核生物基因组设计与化学合成方面的系列重大突破:完成了4条真核生物酿酒酵母染色体的从头设计与化学合成,此前国际同行奋斗多年才合成了一条,这项研究将开启“再造生命”的新纪元。
“这一系列最新研究对于创造首个全合成真核细胞基因组具有里程碑式的意义。”加州拉霍亚Synthetic Genomics公司的Daniel Gibson在写给《科学》杂志的邮件中这样评价这系列突破性研究,也就是他创造了首条人工合成细菌基因组及首个人工合成细胞。他为这系列研究写了一篇编辑评论文章,但是并没有参与相关工作。
复旦大学医学院教授陈力看到杂志发表的文章后激动不已,他对第一财经记者表示:“这是继合成原核生物染色体之后的又一里程碑式突破,未来可以对生命解构、重构和组装。真核的难度比起原核是指数级的,可以认为是合成生物学的2.0版本,这个过程的建立,会产生新的解决方案和新的需求。”
陈力的博士论文就是关于酵母的,对酵母有着深厚的感情。“酵母是单细胞真菌,它的细胞有两种生长形态,单倍体和二倍体。相比原核生物只有一套基因而言,真核生物拥有两套基因和核细胞,因此真核生物的合成更为复杂。”
在合成染色体的过程中,科学家们还突破了生物合成方面的多项关键核心技术。汪建表示:“开发系列核心技术成为整个项目的关键基础。”这些关键技术包括,突破了合成型基因组导致细胞失活的难题,设计构建染色体成环疾病模型,开发长染色体分级组装策略,证明人工设计合成的基因组具有可增加、可删减的灵活性等。
这些技术将帮助在全世界的生命科学研究和相关实际应用中大显身手。汪建说:“当合成基因成功导入酵母细胞后,人工菌株展现出与野生型高度相似的生命活性,这预示着人工合成在生物制造,包括医药、能源、环境、农业、工业等领域的无限前景,也为生命再造带来无限可能,也使得国家基因库的存、读、写功能得到完美体现。”
2014年,纽约大学兰贡医学中心酵母遗传学家Jef Boeke及另一个研究小组的科研人员一起合成了首条真核细胞染色体:酿酒酵母染色体Ⅲ的精简版本。此后,为了合成他们的“合成酵母2.0(Sc2.0)”计划中设计的含有1130万对碱基对的酵母基因组,这个任务也是“基因组计划-Write”中的首要任务。
“我们正在进入的真正的基因组学革命是染色体尺度的读和写的交融。”哈佛大学的George Church表示,“这些新工作正是在这个尺度操作的,与改变单个碱基对或者是移植整个基因组相比,一次检测5万对碱基对的作用更合理且更灵活。不久我们就会知道这项技术如何应用于农业和医学领域。”Church参与了“基因组计划-Write”项目,但是并未参与这项最新研究。
从解构到重构
“对于生命很多人类无法理解的东西,现在可以像拼装航模一样,先通过解构,把功能部件分开,根据不同需求,再次进行零件的批量生产和组装。”陈力对第一财经记者表示,“这相当于是在现有的蓝本上做加减法,以前只能够筛选,不能设计,但现在就能通过生命工程进行重构。”
陈力介绍道,以酵母在药物生产方面为例,未来可以把人工合成的有特定功能的基因设计到合成酵母中,或者将有副作用的基因去除,用于疫苗的生产等。“这比人类的自由度要大很多。”他对第一财经记者表示,“这在未来合成食物或者药物等方面都会有重大意义,将影响人类生活的方方面面。转基因食物的时代即将过去,未来就是生物合成食物了,根据人对食物的需求,可以合成具有特定功能的食物。”
中科院上海有机化学研究所生物与化学交叉研究中心研究员陈椰林对第一财经记者表示:“合成生物学是一个很重要的发展方向,合成染色体就能合成整个基因组,那么以后可以合成新的物种或者已经灭绝的物种就不是没有可能的事情了。侏罗纪公园也不再是梦想。”陈椰林还表示,在一些特殊领域正在加大对合成生物学的投入,比如改造酿酒酵母等。
“这项研究发现是中国在合成生物学领域取得的突破性成果,进一步奠定了我国在这一领域的国际地位。”中科院院士、华大基因学院院长杨焕明表示,“不难看出我们在生命科学研究领域的巨大进步。在酿酒酵母设计与合成研究中,我们已由‘跟跑’转为‘并跑’,今后还有可能‘领跑’。”
此前,基因修饰的酵母已经用来制作疫苗、药物和特定的化合物,这些新成果的发表意味着化学物质设计定制酵母生命体成为可能,产物范围也将被拓展。随着人工合成酵母的推广应用,必将显著提高其在工业生产、药物制造等方面的效率与质量。
汪建向第一财经记者等表示:“深圳国家基因库已建成世界级的基因合成平台。这必将引领该领域的发展。我们建议宣布更加重大的生物合成计划,进行包括万种噬菌体、百个生物信号通路、十种真核多细胞生物及人类基因组关键染色体区段的全人工合成,建立更加完善的技术平台,奠定领域领先优势。”
“合成生物学是一个机会,但也是挑战。因为它的发生可能比我们的想象速度要更快,未来10年或者20年,人们的生活可能就完全被改变了。”陈力对第一财经记者表示,“Crispr基因编辑技术是编辑,但是合成生物是创造。你给它无生命的原料和基因图谱,它就能给你创造出生命,这难道不是很神奇的事情?”
陈力相信,虽然现在人类还处于模仿阶段,但不久的将来,就创造出新的生物。“汪建等科学家正在影响着年轻一代,下一代人才是推动未来医学模式发展的主力军。”
美国研究机构BCC Research报告显示,2016年全球合成生物市场规模接近40亿美元,到2021年,这一规模将增加近两倍,达到114亿美元,五年内每年增速约24%。英国合成生物学领导理事会(SBLC)去年曾发布战略计划,称到2030年,英国合成生物学规模将达到100亿欧元的市场。













